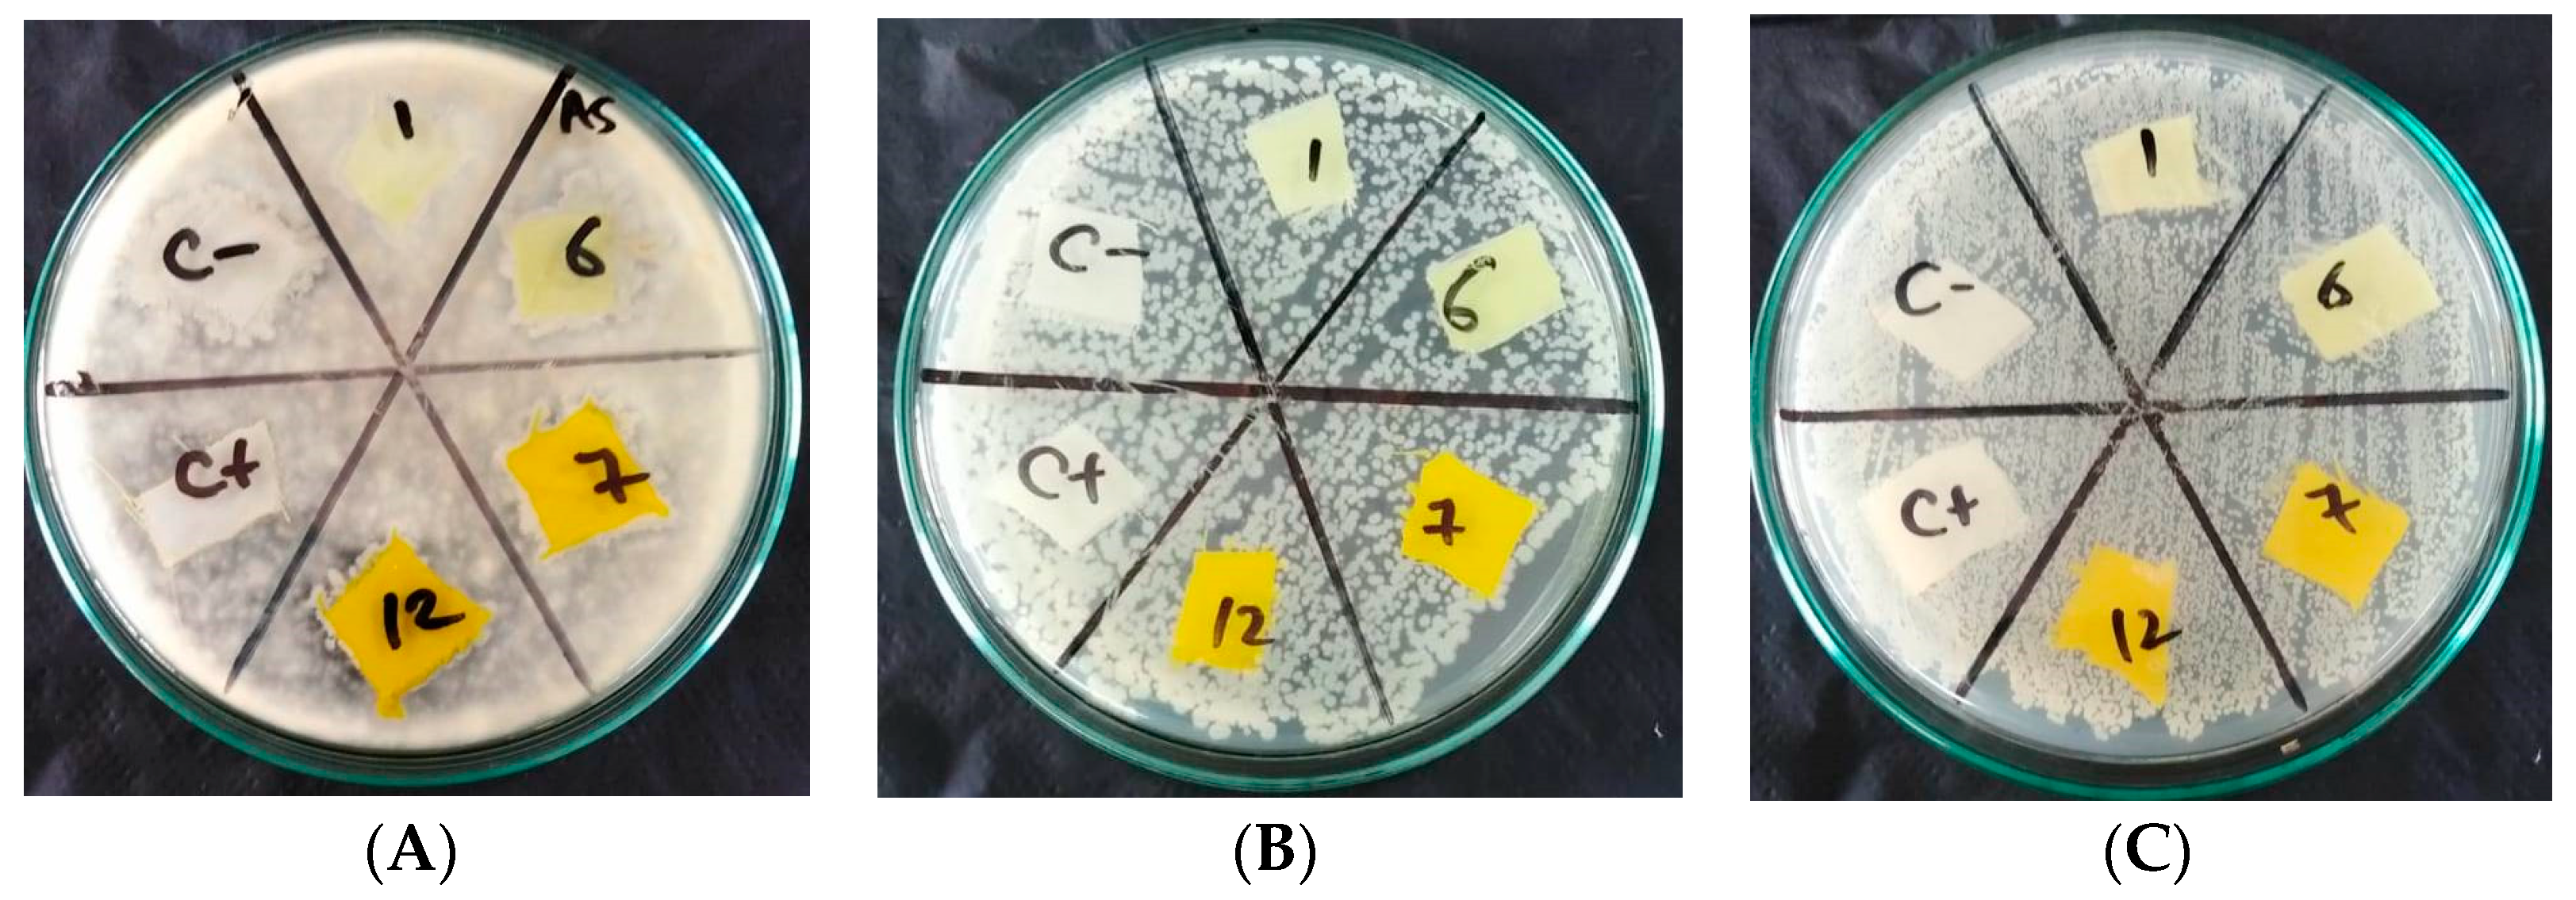
Polymers 15 01845 g011 Polymers 15 01845 g011
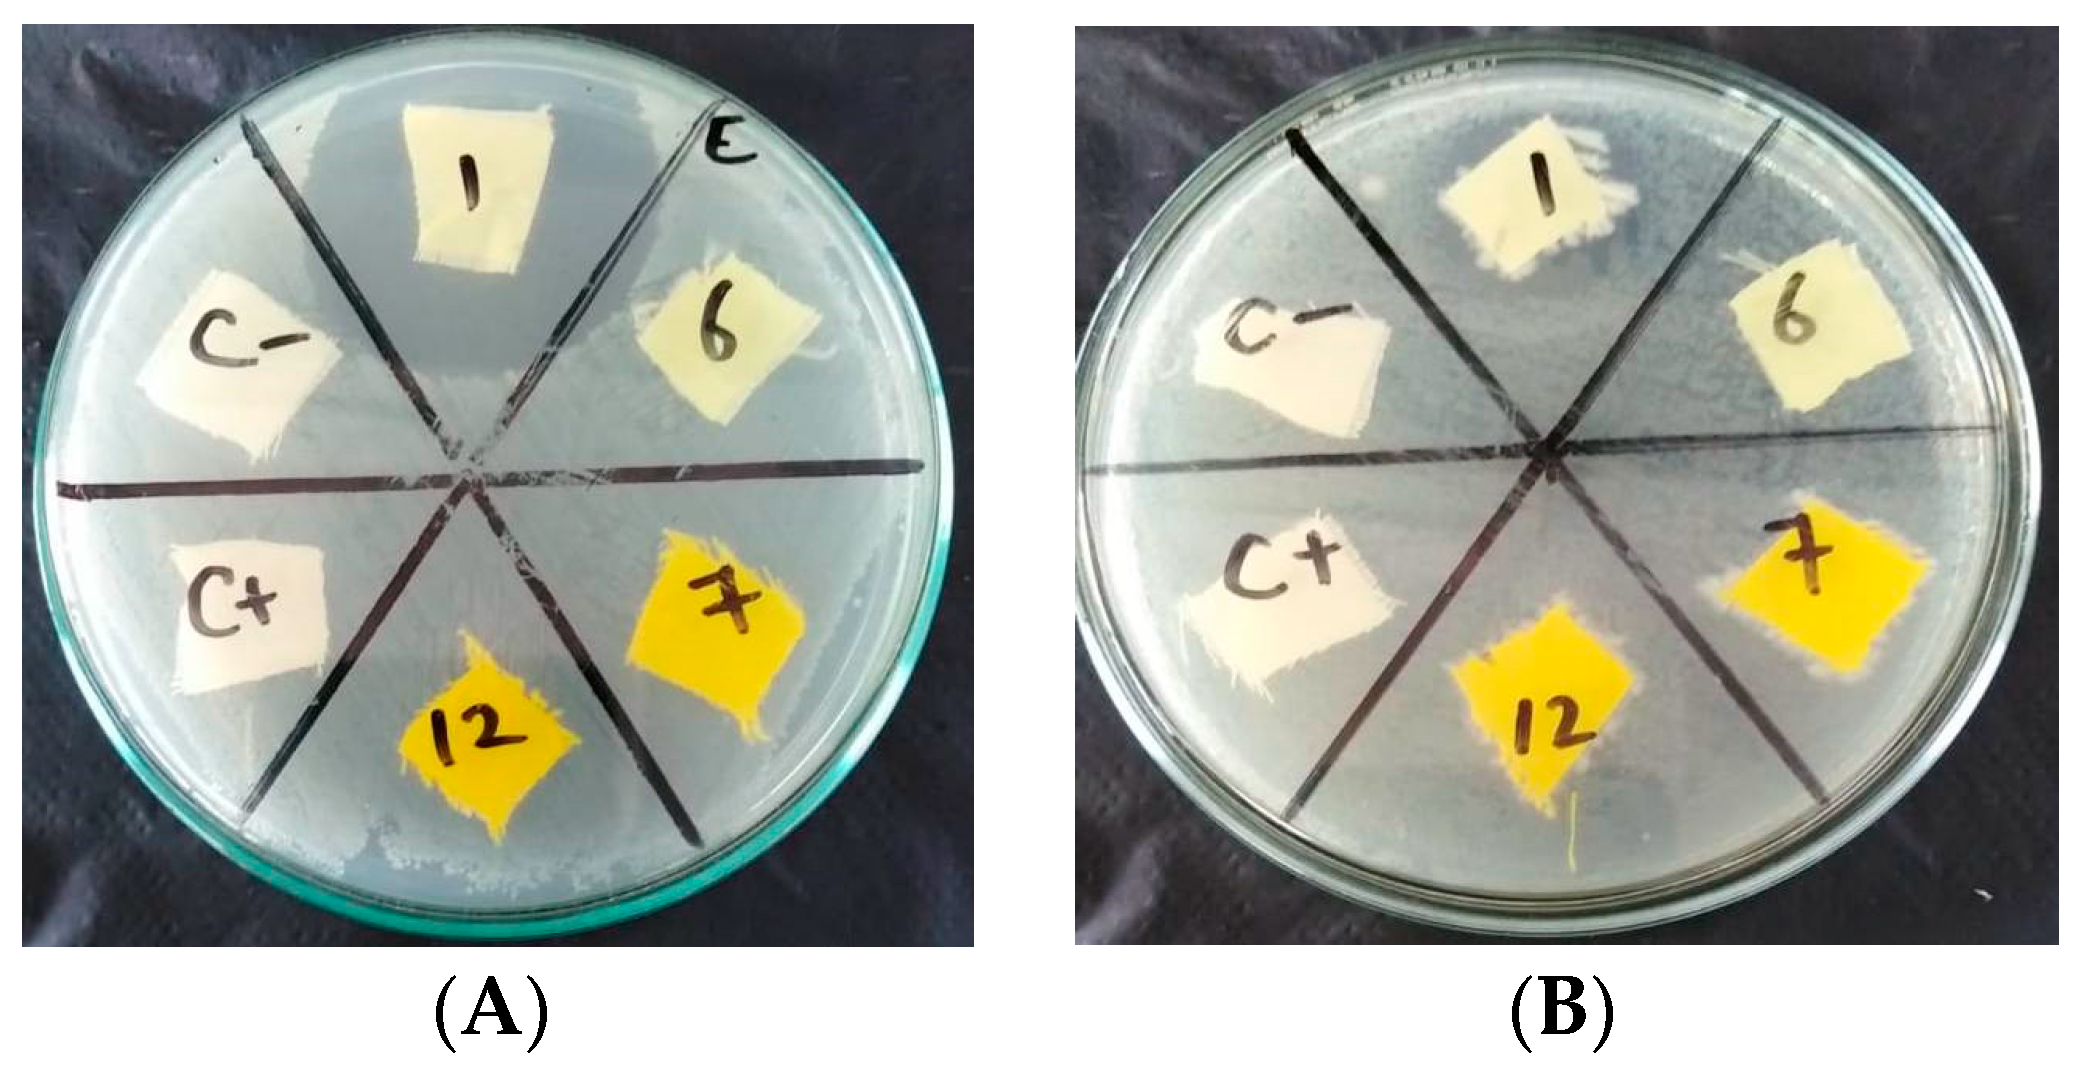
Polymers 15 01845 g012 Polymers 15 01845 g012

Can Novel Synthetic Disperse Dyes for Polyester Fabric Dyeing Provide Added Value?
Abstract
1. Introduction
2. Materials
3. Dyeing
Dye Uptake
4. Fastness Properties
5. Antioxidant Activity
6. In Vitro Cytotoxicity Screening
7. Antimicrobial Activities of the New Synthesized Disperse Dyes
8. Treatment of Polyester Fabrics with TiO2 NPs or ZnO NPs
8.1. Antimicrobial Activity of Untreated and Treated Polyester Fabrics with TiO2 NPs or ZnO NPs
8.1.1. Antimicrobial Activity of Untreated Polyester Fabrics
8.1.2. Antimicrobial Activity of Treated Polyester Tabrics with TiO2 NPs or ZnO NPs
8.2. UV Protective Properties of Untreated and Treated Polyester Fabrics with ZnO NPs or TiO2 NPs
8.3. Light Fastness of Untreated and Treated Polyester Fabrics with TiO2 NPs or ZnO NPs
8.4. Self-Cleaning of Untreated and Treated Polyester Fabrics with TiO2 NPs or ZnO NPs
9. Conclusions
Author Contributions
Funding
Institutional Review Board Statement
Informed Consent Statement
Data Availability Statement
Conflicts of Interest
References
- Al-Etaibi, A.M.; El-Apasery, M.A. Microwave-Assisted Synthesis of Azo Disperse Dyes for Dyeing Polyester Fabrics: Our Contributions over the Past Decade. Polymers 2022, 14, 1703. [Google Scholar] [CrossRef] [PubMed]
- Al-Etaibi, A.M.; El-Apasery, M.A. Facile Synthesis of Novel Disperse Dyes for Dyeing Polyester Fabrics: Demonstrating Their Potential Biological Activities. Polymers 2022, 14, 3966. [Google Scholar] [CrossRef]
- Al-Etaibi, A.M.; El-Apasery, M.A. Ultrasonic Dyeing of Polyester Fabric with Azo Disperse Dyes Clubbed with Pyridononesand Its UV Protection Performance. Chemistry 2021, 3, 889–895. [Google Scholar] [CrossRef]
- Ghaffar, A.; Adeel, S.; Habib, N.; Jalal, F.; Ul-Haq, A.; Munir, B.; Ahmad, A.; Jahangeer, M.; Jamil, Q. Effects of Microwave Radiationon Cotton Dyeing with Reactive Blue 21 Dye. Pol. J. Environ. Stud. 2019, 28, 1687–1691. [Google Scholar] [CrossRef] [PubMed]
- Stefanidis, G.D.; Muñoz, A.N.; Sturm, G.S.J.; Stankiewicz, A. A Helicopter View of Microwave Applicationto Chemical Processes: Reactions, Separations, and Equipment Concepts. Rev.Chem.Eng. 2014, 30, 233–259. [Google Scholar] [CrossRef]
- Rana, K.K.; Rana, S. Microwave Reactors: A Brief Reviewon Its Fundamental Aspects and Applications. Open Access Libr. J. 2014, 1, 686. [Google Scholar] [CrossRef]
- Yoon, S.; Kim, H.; Oh, N.; Kim, S.; Kumar, S.; Koh, J. Synthesis and application of high-washability 4-amino-4′-fluorosulfonylazobenzene disperse dyes to cellulose diacetate for high color fastness. Fibers Polym. 2021, 22, 3075–3081. [Google Scholar] [CrossRef]
- Ahmed, S.M.; Aly, A.A.; El-Apasery, M.A.; Ragai, S.M. Decolorization of Reactive Dyes, Part VII: Eco-Friendly Approach of Reactive Dye Effluents Decolorization Using Geopolymer Cement Based on Metakaolin-Slag mixes. Egypt. J. Chem. 2022, 65, 689–694. [Google Scholar] [CrossRef]
- Adeel, S.; Shahid, S.; Khan, S.G.; Rehman, F.; Muneer, M.; Zube, M.; Akhtar, H. Eco-friendly disperse dyeing of ultraviolet-treated polyester fabric using disperse yellow 211. Pol. J. Environ. Stud. 2018, 27, 1935–1939. [Google Scholar] [CrossRef]
- Rehman, F.; Adeel, S.; Saif, M.J.; Khosa, M.K.; Anjum, M.N.; Kamran, M.; Zuber, M.; Asif, M. Ultrasonic assisted improvement in dyeing behaviour of polyester fabric using Disperse Red 343. Pol. J. Environ. Stud. 2020, 29, 261–265. [Google Scholar] [CrossRef]
- Yoon, S.; Choi, B.; Rahman, M.M.; Kumar, S.; Kabir, S.M.M.; Koh, J. Dyeing of polyester with 4-arylazo-5-pyrazolone dyes containing fluoro sulfonyl group and application of environment-friendly after treatment for their high color fastness. Materials 2019, 12, 4209. [Google Scholar] [CrossRef]
- Rosa, R.; Veronesi, P.; Leonelli, C. A review on combustion synthesis intensification by means of microwave energy. Chem. Eng. Process. Process Intensif. 2013, 71, 2–18. [Google Scholar] [CrossRef]
- Collins, J.M.; Collins, M.J. Novel method for enhanced solid-phase peptide synthesis using microwave energy. Biopolymers 2003, 71, 361. [Google Scholar]
- Kappe, C.O.; Dallinger, R.D. The impact of microwave synthesis on drug discovery. Nat. Rev. Drug Discov. 2006, 5, 51–64. [Google Scholar] [CrossRef]
- Kappe, C.O.; Stadler, A.; Dallinger, D.; Strohmeier, G.; Perez, R.; Zbruyev, O.I.; Stiasni, N.; Walla, P.; Gorobets, N.; Yousefi, B.; et al. Adventures in microwave-assisted organic synthesis: Contributions from the Kappe laboratory 2000–2005. Nato. Sci. Ser. Ii-Math. 2008, 246, 225–251. [Google Scholar]
- Murray, J.K.; Gellman, S.H. Application of microwave irradiation to the synthesis of 14-helical β-peptides. Org. Lett. 2005, 7, 1517–1520. [Google Scholar] [CrossRef]
- Chen, Y.; Fan, B.; Yang, B.; Ma, W.; Liu, G.; Li, H. Microwave sintering and fracture behavior of zirconia ceramics. Ceram. Int. 2019, 45, 17675–17680. [Google Scholar] [CrossRef]
- Huang, K.; Zheng, J.; Yuan, W.; Wang, X.; Song, Q.; Li, Y.; Crittenden, J.C.; Wang, L.; Wang, J. Microwave-assisted chemical recovery of glass fiber and epoxy resin from non-metallic components in waste printed circuit boards. WasteManag. 2021, 124, 8–16. [Google Scholar] [CrossRef]
- Serdar, G.; Demir, E.; Bayrak, S.; Sökmen, M. New Approaches for Effective Microwave Assisted Extraction of Caffeine and Catechins from Green Tea. Int. J. Second. Metab. 2016, 3, 3–13. [Google Scholar] [CrossRef]
- Orlik, K.; Lorgouilloux, Y.; Marchet, P.; Thuault, A.; Jean, F.; Rguiti, M.; Courtois, C. Influence of microwave sintering on electrical properties of BCTZ lead free piezoelectric ceramics. J. Eur. Ceram. Soc. 2020, 40, 1212–1216. [Google Scholar] [CrossRef]
- Ramesh, S.; Zulkifli, N.; Tan, C.; Wong, Y.; Tarlochan, F.; Teng, W.; Sopyan, I.; Bang, L.; Sarhan, A.A.D. Comparison between microwave and conventional sintering on the properties and microstructural evolution of tetragonal zirconia. Ceram. Int. 2018, 44, 8922–8927. [Google Scholar] [CrossRef]
- Vialkova, E.; Obukhova, M.; Belova, L. Microwave irradiation in technologies of wastewater and wastewater sludge treatment: A review. Water 2021, 13, 1784. [Google Scholar] [CrossRef]
- Okada, Y.; Hihara, T.; Morita, Z. Analysis of the catalytic fading of pyridone-azo disperse dyes on polyester using the semi-empirical, molecular orbital PM5 method. Dyes Pigments 2008, 78, 179–198. [Google Scholar] [CrossRef]
- El-Apasery, M.A. Synthesis of some azo disperse dyes by the use of focused microwave heating. Pol. J. Appl. Chem. 2006, 50, 75–81. [Google Scholar]
- Yin, C. Microwave-assisted pyrolysis of biomass for liquid biofuels production. Bioresour. Technol. 2012, 120, 273–284. [Google Scholar] [CrossRef]
- Bridgwater, A.V. Review of fast pyrolysis of biomass and product upgrading. Biomass Bioenergy 2012, 38, 68–94. [Google Scholar] [CrossRef]
- Wei, R.; Wang, P.; Zhang, G.; Wang, N.; Zheng, T. Microwave-responsive catalysts for wastewater treatment: A review. Chem. Eng. J. 2020, 382, 122781. [Google Scholar] [CrossRef]
- Remya, N.; Lin, J.-G. Current status of microwave application in wastewater treatment—A review. Chem. Eng. J. 2011, 166, 797–813. [Google Scholar] [CrossRef]
- Mudhoo, A.; Sharma, S.K.; Sharma, S.K. Microwave Irradiation Technologyin Waste Sludgeand Wastewater Treatment Research. Crit. Rev. Environ. Sci. Technol. 2011, 41, 999–1066. [Google Scholar] [CrossRef]
- Jang, H.K.; Doh, S.J.; Lee, J.J. Eco-friendly dyeing of poly (trimethylene terephthalate) with temporarily solubilized azo disperse dyes based on pyridone derivatives. FibersPolym. 2009, 10, 315–319. [Google Scholar] [CrossRef]
- Tsai, P.C.; Wang, I.J. A facile synthesis of some new pyrazolo [1, 5-a] pyrimidine heterocyclic disazo dyes and an evaluation of their solvatochromic behaviour. Dyes Pigments 2007, 74, 578–584. [Google Scholar] [CrossRef]
- El-Apasery, M.A. Solvent-free one-pot synthesis of some azo disperse dyes under microwave irradiation: Dyeing of polyester fabrics. J. Appl. Polym. Sci. 2008, 109, 695–699. [Google Scholar] [CrossRef]
- Al-Zaydi, K.M.; Borik, R.M.; Elnagdi, M.H. Studies with arylhydrazonopyridinones: Synthesis of new arylhydrazono thieno [3, 4-c] pyridinones as novel D2T2 dye class; classical verse green methodologies. Ultrason.Sonochem. 2009, 16, 660–668. [Google Scholar] [CrossRef]
- Devi, A.S.; Kaping, S.; Vishwakarma, J.N. A facile environment-friendly one-pot two-step regioselective synthetic strategy for 3, 7-diarylpyrazolo 1, 5-a pyrimidines related to zaleplon and 3, 6-diarylpyrazolo 1, 5-a pyrimidine-7-amines assisted by KHSO _ 4 4 in aqueous media. Mol. Divers. 2015, 19, 759–771. [Google Scholar] [CrossRef]
- El-Bayouki, M.; AbdelHameed, K.; Asyouni, W.M.; Mohamed, Y.A.; Aly, M.M.; Abbas, S.Y. Novel 4 (3H)-quinazolinones containing biologically active thiazole, pyridinone and chromene of expected antitumor and antifungal activities. Eur. J. Chem. 2011, 2, 455–462. [Google Scholar] [CrossRef]
- Okada, Y.; Hihara, T.; Morita, Z. Analysis of the photofading of phenylazo-aniline and phenylazo-pyridone disperse dyes on poly (ethylene terephthalate) substrate using the semiempirical molecular orbital PM5 method. Dyes Pigments 2008, 79, 111–125. [Google Scholar] [CrossRef]
- Okada, Y.; Hihara, T.; Morita, Z. Photofading of phenylazo-aniline, -pyridone and -quinolone disperse dyes on a nylon 6 substrate. Color. Technol. 2009, 125, 86–98. [Google Scholar] [CrossRef]
- Darwish, E.; Mahmoud, F.F.; Altalbawy, F.M.A. Synthesis and antimicrobial evaluation of some new pyrazole, fused pyrazolo [1, 5-a]-pyrimidine and pyrazolo [1, 5-d] pyrimido [4, 5-d][1, 2, 3] triazine derivatives. AsianJ. Chem. 2012, 24, 2997–3002. [Google Scholar]
- El-Adasy, A.A.A.M.; Kamel, M.M.; Saleh, M.O.; Hussein, A.M.; El-Apasery, M.A. Disperse dyes based on pyrazolopyrimidinones I: Their dyeing applications and antimicrobial activities. Int. J. ChemTech Res. 2016, 9, 31–38. [Google Scholar]
- Díaz-Ortiz, Á.; Prieto, P.; DelaHoz, A. A Critical Overviewonthe Effect of Microwave Irradiationin Organic Synthesis. Chem. Rec. 2019, 19, 85. [Google Scholar] [CrossRef]
- El-Apasery, M.A.; Hussein, A.M.; El-Adasy, A.A.M.; Saleh, M.O.; Kamel, M.M. Microwave Assisted Synthesisof Some Azo Disperse Dyes with Antibacterial Activities. Part1. Egypt J. Chem. 2019, 62, 1253–1259. [Google Scholar]
- Al-Etaibi, A.; El-Apasery, M.A.; Al-Awadi, N. The effect of dispersing agent on the dyeing of polyester fabrics with disperse dyes derived from 1, 4-diethyl-2, 6-dioxo-1, 2, 5, 6-tetrahydropyridine-3-carbonitrile. Eur. J. Chem. 2013, 4, 240–244. [Google Scholar] [CrossRef]
- Al-Etaibi, A.; Al-Awadi, N.A.; El-Apasery, M.A.; Ibrahim, M.R. Synthesis of some novel pyrazolo [1, 5-a] pyrimidine derivatives and their application as disperse dyes. Molecules 2011, 16, 5182–5193. [Google Scholar] [CrossRef] [PubMed]
- Al-Etaibi, A.; El-Apasery, M.A.; Ibrahim, M.R.; Al-Awadi, N.A. A facile synthesis of new monoazo disperse dyes derived from 4-hydroxyphenylazopyrazole-5-amines: Evaluation of microwave assisted dyeing behavior. Molecules 2012, 17, 13891–13909. [Google Scholar] [CrossRef] [PubMed]
- Al-Etaibi, A.; El-Apasery, M.A.; Mahmoud, H.M.; Al-Awadi, N.A. One-pot synthesis of disperse dyes under microwave irradiation: Dyebath reuse in dyeing of polyester fabrics. Molecules 2012, 17, 4266–4280. [Google Scholar] [CrossRef]
- Al-Etaibi, A.; El-Apasery, M.A.; Mahmoud, H.; Al-Awadi, N. Synthesis, characterizationandantimicrobialactivity, andapplicationsofnewazopyridonedispersedyesonpolyesterfabric. Eur. J. Chem. 2014, 5, 321–327. [Google Scholar] [CrossRef]
- Al-Etaibi, A.M. SynthesisandAntimicrobialActivityofsomeDisperseDyesderivedfromPyridones. Int. J. ChemTechRes. 2019, 12, 129–133. [Google Scholar] [CrossRef]
- Al-Etaibi, A.M.; El-Apasery, M.A. Dyeing performance of disperse dyes on polyester fabrics using eco-friendly carrier and their antioxidant and anticancer activities. Int. J. Environ. Res. Public Health 2019, 16, 4603. [Google Scholar] [CrossRef]
- Al-Etaibi, A.M.; El-Apasery, M.A. Nano TiO2 imparting multifunctional performance on dyed polyester fabrics with some disperse dyes using high temperature dyeing as an environmentally benign method. Int. J. Environ. Res. Public Health 2020, 17, 1377. [Google Scholar] [CrossRef]
- Mashaly, H.M.; Abdelghaffar, R.A.; Kamel, M.M.; Youssef, B.M. Dyeing of polyester fabric using nano disperse dyes and improving their light fastness using ZnO nano powder. Ind. J. Sci. Technol. 2012, 7, 960–967. [Google Scholar] [CrossRef]
- Al-Etaibi, A.M.; El-Apasery, M.A. A comprehensive review on the synthesis and versatile applications of biologically active pyridone-based disperse dyes. Int. J. Environ. Res. Public Health 2020, 17, 4714. [Google Scholar] [CrossRef]
- Dostanić, J.; Valentić, N.V.; Ušćumlić, G.; Mijin, D. Synthesis of 5-(substituted phenylazo)-6-hydroxy-4-methyl-3-cyano-2-pyridones from ethyl 3-oxo-2-(substituted phenylazo) butanoates. J. Serb. Chem. Soc. 2011, 76, 499–504. [Google Scholar] [CrossRef]
- Mijin, D.Ž.; Baghbanzadeh, M.; Reidlinger, C.; Kappe, C.O. The microwave-assisted synthesis of 5-arylazo-4, 6-disubstituted-3-cyano-2-pyridone dyes. Dyes Pigments 2010, 85, 73–78. [Google Scholar] [CrossRef]
- Gaffer, H.E.; Shkra, S.; Abbas, D.; Allam, E.A. Synthesis and antimicrobial activity of some new sulphonamide disperse dyes and their applications to polyester fibres. J. Appl. Polym. Res. 2013, 9, 4051–4058. [Google Scholar]
- Ahmed, K.A.; Elhennawy, H.M.; Elkashouti, M.A. Microwave Assiststhe Synthesisof Pyridoneazo Dyesandtheir Applicationin Polyester Printing. Res. J. Chem. Sci. 2012, 2, 14–19. [Google Scholar]
- Mijin, D.; Ušćumlić, G.; Perišić-Janjić, N.; Trkulja, I.; Radetić, M.; Jovančić, P. Synthesis, properties and color assessment of some new 5-(3-and 4-substituted phenylazo)-4, 6-dimethyl-3-cyano-2-pyridones. J. Serb. Chem. Soc. 2006, 71, 435–444. [Google Scholar] [CrossRef]
- Al-Etaibi, A.M.; El-Apasery, M.A.; Kamel, M.M. Dyeing of polyester with disperse dyes: Part 1. Antimicrobial activity and dyeing performance of some disperse dyes. Int. J. Curr. Microbiol. Appl. Sci. 2015, 4, 923–928. [Google Scholar]
- Al-Etaibi, A.M.; El-Apasery, M.A. Dyeing of polyester with disperse dyes: Part 3. Characterization of ZnO nanoparticles treated polyester fabrics for antibacterial, self-cleaning and UV protective. Int. J. ChemTech Res. 2016, 9, 162–169. [Google Scholar]
- Al-Etaibi, A.M.; Alnassar, H.S.; El-Apasery, M.A. Dyeing of polyester with disperse dyes: Part2. Synthesis and dyeing characteristics of some azo disperse dyes for polyester fabrics. Molecules 2016, 21, 855. [Google Scholar] [CrossRef]
- Al-Etaibi, A.M.; Kamel, M.M.; El-Apasery, M.A. Synthesis and applications of new aminothienopyridazines disperse dyes on polyester fabric. Int. J. Curr. Microbiol. Appl. Sci. 2014, 3, 826–832. [Google Scholar]

| Dye | L* | a* | b* | C* | h* | Color Strength (K/S) | Ref. |
|---|---|---|---|---|---|---|---|
| 3 | - | - | - | - | - | 2.12 | [42] |
| 5 | - | - | - | - | - | 3.79 | |
| 7a | - | - | - | - | - | 5.95 | |
| 7b | - | - | - | - | - | 5.81 | |
| 7c | - | - | - | - | - | 4.64 | |
| 7d | - | - | - | - | - | 4.73 | |
| 10 | - | - | - | - | - | 0.84 | [44] |
| 11 | - | - | - | - | - | 4.35 | |
| 12a | - | - | - | - | - | 9.78 | |
| 12b | - | - | - | - | - | 15.72 | |
| 12c | - | - | - | - | - | 14.92 | |
| 12d | - | - | - | - | - | 21.08 | |
| 12f | - | - | - | - | - | 23.55 | |
| 12g | - | - | - | - | - | 20.93 | |
| 12h | - | - | - | - | - | 16.52 | |
| 18a | 83.76 | 2.86 | 108.46 | 108.5 | 88.49 | 27.39 | [46] |
| 18b | 59.35 | 45.74 | 77.22 | 89.75 | 59.36 | 30.29 | |
| 18c | 67.77 | 42.60 | 92.15 | 101.52 | 65.19 | 30.28 | |
| 18d | 74.91 | 31.22 | 74.73 | 80.99 | 67.32 | 8.88 | |
| 18e | 82.00 | 8.57 | 109.48 | 109.81 | 85.52 | 28.91 | |
| 18f | 81.22 | 11.00 | 109.18 | 109.73 | 84.25 | 28.09 | |
| 18g | 79.46 | 9.28 | 98.8 | 99.23 | 84.63 | 27.31 | |
| 18h | 76.33 | 4.47 | 93.78 | 93.88 | 87.27 | 19.38 | |
| 18i | 78.41 | −0.56 | 87.34 | 87.34 | 90.37 | 12.63 | |
| 20a | 42.34 | 37.11 | 13.96 | 39.47 | 20.79 | 10.05 | [60] |
| 20b | 39.05 | 45.68 | 18.28 | 49.32 | 22.07 | 16.03 | |
| 20c | 45.50 | 42.14 | 7.91 | 47.89 | 11.13 | 7.84 | |
| 20d | 33.37 | 25.63 | −16.25 | 31.42 | 327.43 | 9.79 | |
| 21a | 77.22 | −20.37 | 53.94 | 57.66 | 110.69 | 17.59 | [57] |
| 21b | 67.58 | 9.29 | 61.34 | 62.04 | 81.39 | 16.69 |
| Dye No. | K/S | L* | a* | b* | Ref. |
|---|---|---|---|---|---|
| Dyeing at 100 °C | |||||
| 18h | 4.74 | 80.06 | −4.58 | 68.35 | [46] |
| 18i | 3.46 | 80.35 | −5.20 | 61.82 | |
| 21a | 12.21 | 84.81 | −14.26 | 52.16 | [57] |
| 21b | 8.97 | 78.08 | −0.21 | 51.20 | |
| US dyeing at 80 °C | |||||
| 18h | 9.07 | 80.58 | −3.80 | 78.86 | [3] |
| Dyeing at 130 °C | |||||
| 18h | 19.38 | 76.33 | 4.47 | 93.78 | [46] |
| 18i | 12.63 | 78.41 | −0.56 | 87.34 | |
| 21a | 17.59 | 77.22 | −20.37 | 53.94 | [57] |
| 21b | 16.69 | 67.58 | 9.29 | 61.34 | |
| Dye No. | Color Shade on Polyester Fabrics | Washing Fastness | Perspiration Fastness | Rubbing Fastness | Light Fastness | Ref. | ||
|---|---|---|---|---|---|---|---|---|
| SC | Acidic | Alkaline | ||||||
| SC | SC | Dry | Wet | |||||
| 3 | Yellowish-orange | 5 | 4 | 5 | NE | NE | 4 | [42] |
| 5 | Pale orange | 5 | 5 | 5 | NE | NE | 2 | |
| 7a | Dark orange | 5 | 5 | 5 | NE | NE | 2–3 | |
| 7b | Dark orange | 5 | 4 | 5 | NE | NE | 3 | |
| 7c | Orange | 4 | 4–5 | 5 | NE | NE | 2–3 | |
| 7d | Orange | 4–5 | 5 | 5 | NE | NE | 2–3 | |
| 10 | Yellowish brown | 5 | 4 | 5 | NE | NE | 3–4 | [44] |
| 11 | Pale brown | 5 | 5 | 5 | NE | NE | 5–6 | |
| 12a | Yellow | 5 | 5 | 5 | NE | NE | 3–4 | |
| 12b | Yellow | 5 | 5 | 5 | NE | NE | 3 | |
| 12c | Yellow | 5 | 4 | 5 | NE | NE | 3 | |
| 12d | Yellowish brown | 4 | 5 | 5 | NE | NE | 3 | |
| 12f | Yellowish orange | 5 | 5 | 5 | NE | NE | 2–3 | |
| 12g | Orange | 5 | 5 | 5 | NE | NE | 3 | |
| 12h | Orange | 5 | 5 | 5 | NE | NE | 6 | |
| 18a | Yellow | 5 | 5 | 5 | NE | NE | 4 | [46] |
| 18b | Dark orange | 5 | 5 | 5 | NE | NE | 2 | |
| 18c | Orange | 5 | 5 | 5 | NE | NE | 5 | |
| 18d | Orange | 5 | 5 | 5 | NE | NE | 2 | |
| 18e | Yellow | 5 | 5 | 4–5 | NE | NE | 3–4 | |
| 18f | Dark Yellow | 5 | 3–4 | 3 | NE | NE | 3–4 | |
| 18g | Very dark yellow | 5 | 5 | 5 | NE | NE | 5 | |
| 18h | Deep greenish yellow | 5 | 5 | 5 | 5 | 5 | 4–5 | |
| 18i | Orange yellow | 5 | 5 | 5 | 5 | 5 | 4 | |
| 20a | Reddish-orange | 5 | 5 | 5 | NE | NE | 3–4 | [60] |
| 20b | Red | 4–5 | 5 | 5 | NE | NE | 4 | |
| 20c | Pink | 5 | 5 | 5 | NE | NE | 3–4 | |
| 20d | Violet | 5 | 5 | 5 | NE | NE | 4 | |
| 21a | Greenish-yellow | 4–5 | 5 | 5 | 5 | 5 | 3 | [57] |
| 21b | Yellowish-orange | 4–5 | 5 | 5 | 5 | 5 | 3–4 | |
| Dye No. | Cytotoxic Activity (IC50) | Ref. | |||
|---|---|---|---|---|---|
| MCF-7 | HepG-2 | A-549 | HCT-116 | ||
| 18h | 62.2 ± 4.1 | 23.4 ± 1.2 | 53.6 ± 5.8 | 28 ± 1.9 | [48] |
| 18i | 482 ± 8.9 | 196 ± 3.2 | 456 ± 7.3 | 242 ±3.6 | |
| Dye No. | Inhibition Zone Diameter (Nearest mm) | ||||||||||
|---|---|---|---|---|---|---|---|---|---|---|---|
| Prokaryotic Organisms | Eukaryotic Organisms | ||||||||||
| G− Bacteria | G+ Bacteria | ||||||||||
| E. coli | Serratia sp. | E. cloacae | P. aeruginosa | B. subtilus | B. cereus | S. mutants | S. aureus | C. albicans | S. cerevisiae | A. Niger | |
| 1 | Nil | 4 (0.1) | NE | NE | 11(0.1) | NE | NE | 13(0.3) | 8(0.3) | 1(0.3) | NE |
| 3 | Nil | Nil | NE | NE | 11(0.2) | NE | NE | 12(0.1) | 1(0.2) | Nil | NE |
| 5 | Nil | Nil | NE | NE | 4(0.2) | NE | NE | Nil | 4(0.1) | Nil | NE |
| 7a | Nil | Nil | NE | NE | 7(0.2) | NE | NE | 7(0.2) | 1(0.1) | Nil | NE |
| 7b | Nil | Nil | NE | NE | 2(0) | NE | NE | Nil | 2(0.1) | Nil | NE |
| 7c | Nil | 2 (0.1) | NE | NE | 2(0) | NE | NE | Nil | 3(0.2) | Nil | NE |
| 7d | Nil | Nil | NE | NE | 2(0) | NE | NE | 3(0.1) | 3(0.2) | 1(0.1) | NE |
| 18a | 14 (1) | NE | NE | 16.6 (0.2) | 12.2 (0.5) | NE | NE | 13.3 (0.9) | 14 (0.3) | NE | NE |
| 18b | 10.8 (1.5) | NE | NE | 11.6 (0.2) | 9 (0.3) | NE | NE | 10 (0.3) | 12 (1) | NE | NE |
| 18c | 12.1 (0.7) | NE | NE | 10.6 (0.2) | 10.8 (0.5) | NE | NE | 14.1 (1) | 19.1 (1.3) | NE | NE |
| 18d | 15 (0.5) | NE | NE | 17.2 (1.4) | 14.6 (0.5) | NE | NE | 13.7 (0.6) | 10.1 (0.5) | NE | NE |
| 18e | 10 (0.6) | NE | NE | 9.1 (0.4) | 9 (0.2) | NE | NE | Nil | 12.7 (0.6) | NE | NE |
| 18f | 10 (0.4) | NE | NE | Nil | Nil | NE | NE | 11.1 (0.7) | 20.4 (0.7) | NE | NE |
| 18g | 11 (0.6) | NE | NE | 9.4 (0.2) | 9.7 (0.5) | NE | NE | 10.7 (1.2) | 16.2 (1) | NE | NE |
| 18h | 8 | NE | 11 | NE | Nil | Nil | 12 | Nil | Nil | NE | NE |
| 18i | Nil | NE | 9 | NE | Nil | Nil | 10 | Nil | 8 | NE | NE |
| 20a | NE | NE | NE | NE | NE | NE | NE | NE | NE | NE | NE |
| 20b | NE | NE | NE | NE | NE | NE | NE | NE | NE | NE | NE |
| 20c | NE | NE | NE | NE | NE | NE | NE | NE | NE | NE | NE |
| 20d | NE | NE | NE | NE | NE | NE | NE | NE | NE | NE | NE |
| 21a | 9 | NE | NE | 8 | NE | 11 | NE | 11 | Nil | NE | Nil |
| 21b | 10 | NE | NE | 14 | NE | 18 | NE | 12 | 20 | NE | 24 |
| Dye No. | Inhibition Zone Diameter (Nearest mm) | Ref. | |||||
|---|---|---|---|---|---|---|---|
| G+ Bacteria | G− Bacteria | Fungi | |||||
| Bacillus cereus | Staphylococcus sciuri | Escherichia coli | Pseudomonas aeruginosa | Aspergillus flavus | Penicillium chrysogenum | ||
| 18h | Nil | Nil | Nil | Nil | Nil | Nil | [49] |
| 18i | Nil | Nil | 39 | 24 | Nil | Nil | |
| Dye No. | Inhibition Zone Diameter (Nearest mm) | Ref. | ||||
|---|---|---|---|---|---|---|
| G+Inhibition Zone | G−Inhibition Zone | Yeast | ||||
| Bacillus subtilis | Staphylococcus aureus | Escherichia coli | Klebsiella pneumoniae | Candida albicans | ||
| 21a | Nil | Nil | Nil | Nil | Nil | [57] |
| 21b | Nil | Nil | Nil | Nil | Nil | |
| Dye No. | Treatment | Inhibition Zone Diameter (Nearest mm) | Dye No. | Treatment | Inhibition Zone Diameter (Nearest mm) | ||
|---|---|---|---|---|---|---|---|
| Aspergillus flavus | Penicillium chrysogenum | G+ Bacteria Bacillus subtilis | G− Bacteria Klebsiella pneumoniae | ||||
| 18h | TiO2 NPs | 21 | 19 | 21a | ZnO NPs | 11 | Nil |
| 18i | Nil | Nil | 21b | 8 | 10 | ||
| Dye No. | TiO2% | UPF | UV-A 315–400 nm | UV-B 290–315 nm | Light Fastness | Methylene Blue Stain | Dye No | ZnO% | UPF | Light Fastness | Methyl Red Stain ∆E* |
|---|---|---|---|---|---|---|---|---|---|---|---|
| 18h | Blank | 8.2 | 35.7 | 8.0 | 21a | Blank | 19.42 | ||||
| Untreated | 236.2 | 0.60 | 0.4 | 5–6 | 0% | Untreated | 141.88 | 3–4 | 67.23 | ||
| 1 | 255.3 | 0.70 | 0.3 | 5–6 | 80% | 0.5 | - | 3 | 60.20 | ||
| 2 | 201.6 | 0.80 | 0.4 | 6 | 80% | 1.0 | - | 3 | 59.41 | ||
| 3 | 283.6 | 0.50 | 0.3 | 6 | 75% | 1.5 | - | 3 | 60.88 | ||
| 4 | 278.7 | 0.60 | 0.3 | 6 | 80% | 2.0 | - | 3 | 55.44 | ||
| 5 | 244.6 | 0.60 | 0.3 | 6 | 60% | 2.5 | 173.25 | 3 | 60.36 | ||
| 18i | Untreated | 25.5 | 17.3 | 2.0 | 5 | 10% | 21b | Untreated | 122.37 | 4 | 50.02 |
| 1 | 34.3 | 14.4 | 1.3 | 5 | 80% | 0.5 | - | 5 | 54.42 | ||
| 2 | 34.0 | 15.0 | 1.2 | 5 | 75% | 1.0 | - | 5 | 55.32 | ||
| 3 | 34.9 | 14.3 | 1.2 | 5 | 80% | 1.5 | - | 4 | 54.37 | ||
| 4 | 32.6 | 14.8 | 1.3 | 5 | 70% | 2.0 | - | 4–5 | 53.73 | ||
| 5 | 32.5 | 15.0 | 1.3 | 5–6 | 65% | 2.5 | 190.59 | 4–5 | 60.18 |
Disclaimer/Publisher’s Note: The statements, opinions and data contained in all publications are solely those of the individual author(s) and contributor(s) and not of MDPI and/or the editor(s). MDPI and/or the editor(s) disclaim responsibility for any injury to people or property resulting from any ideas, methods, instructions or products referred to in the content. |
© 2023 by the authors. Licensee MDPI, Basel, Switzerland. This article is an open access article distributed under the terms and conditions of the Creative Commons Attribution (CC BY) license (https://creativecommons.org/licenses/by/4.0/).
Share and Cite
Al-Etaibi, A.M.; El-Apasery, M.A. Can Novel Synthetic Disperse Dyes for Polyester Fabric Dyeing Provide Added Value? Polymers 2023, 15, 1845. https://doi.org/10.3390/polym15081845
Al-Etaibi AM, El-Apasery MA. Can Novel Synthetic Disperse Dyes for Polyester Fabric Dyeing Provide Added Value? Polymers. 2023; 15(8):1845. https://doi.org/10.3390/polym15081845
Chicago/Turabian StyleAl-Etaibi, Alya M., and Morsy Ahmed El-Apasery. 2023. "Can Novel Synthetic Disperse Dyes for Polyester Fabric Dyeing Provide Added Value?" Polymers 15, no. 8: 1845. https://doi.org/10.3390/polym15081845
APA StyleAl-Etaibi, A. M., & El-Apasery, M. A. (2023). Can Novel Synthetic Disperse Dyes for Polyester Fabric Dyeing Provide Added Value? Polymers, 15(8), 1845. https://doi.org/10.3390/polym15081845







